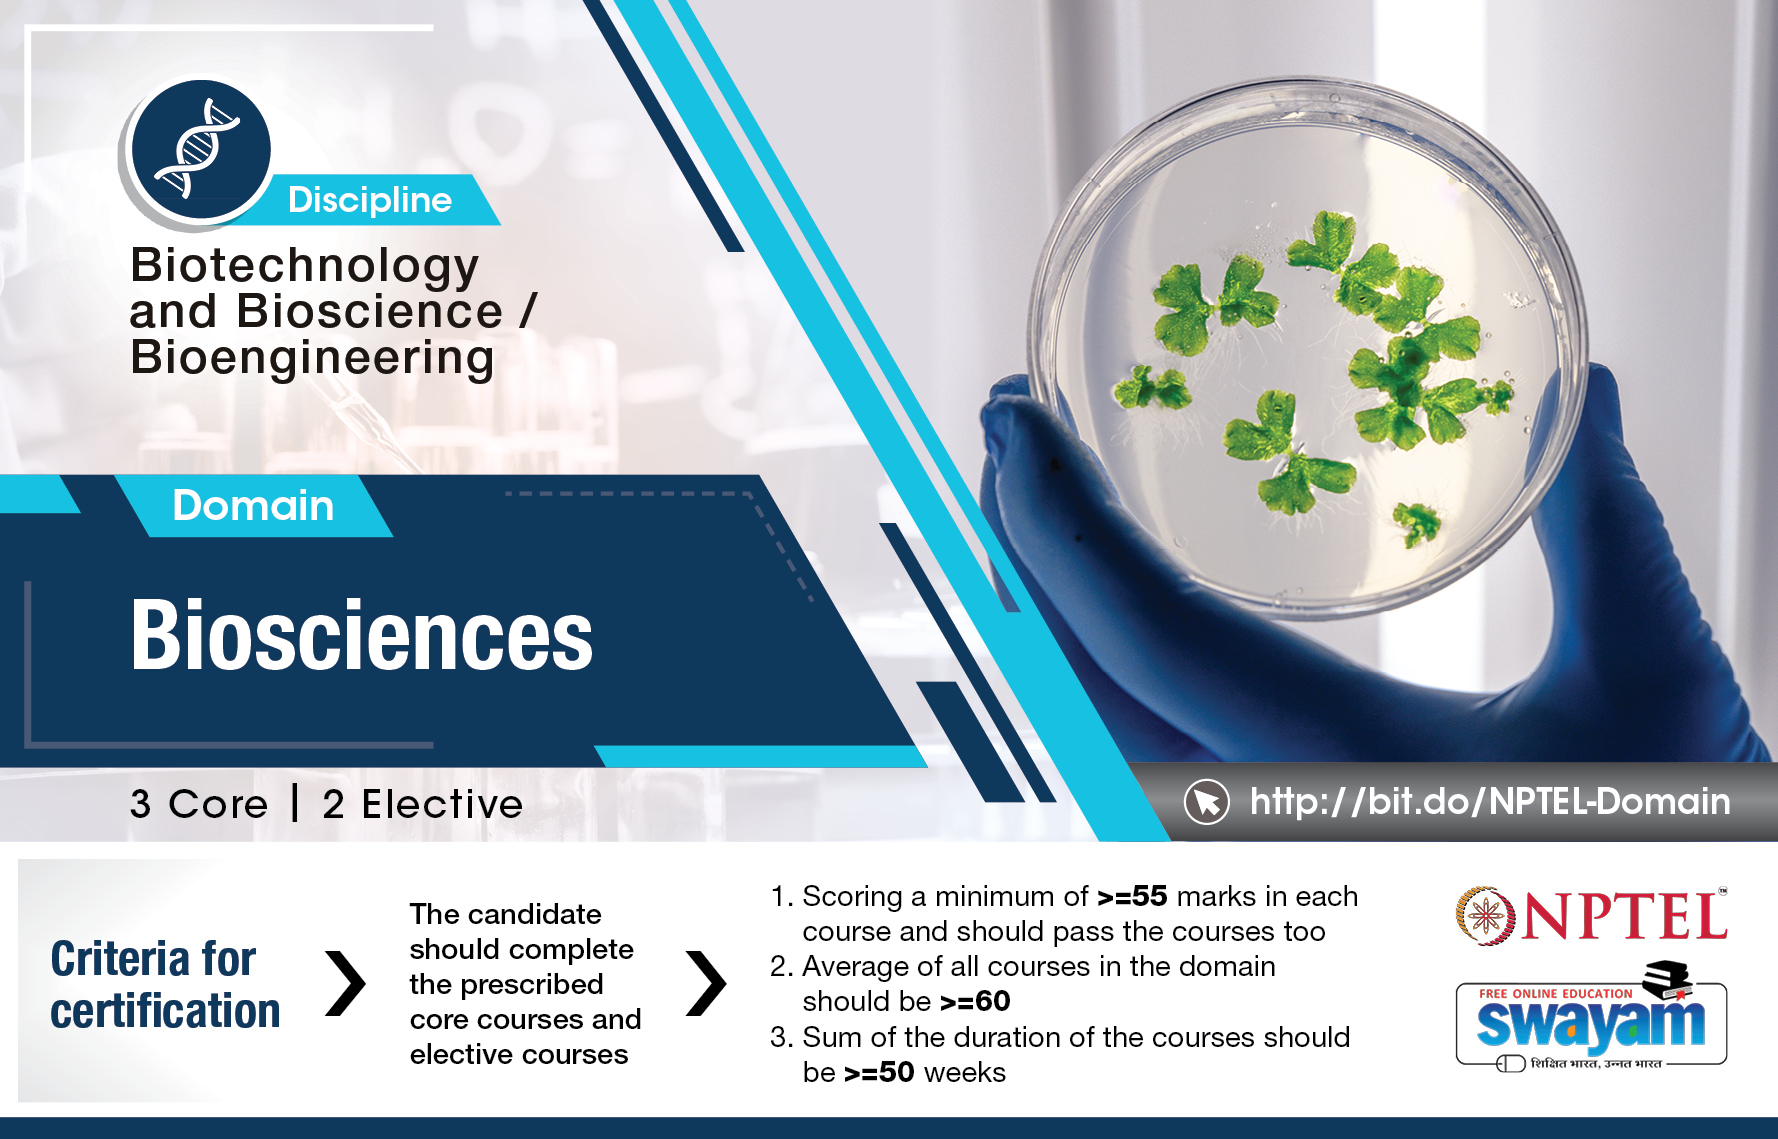

Immunology: Open now for exam registration July 2021!
Thanks & Regards,
Thank you for learning with NPTEL!!
Immunology: Results Published!
- If You have filled G-Form for Name/DOB changes, it will be reflected in your login and E-Certificate after Jan 15th, 2021.
- As announced earlier, hard copies of certificates will not be dispatched.
Feedback for Immunology
Dear student,
We are glad that you have attended the NPTEL online certification course.
We hope you found the NPTEL Online course useful and have started using NPTEL extensively.
In this regard, we would like to have feedback from you regarding our course and whether there are any improvements, you would like to suggest.
We are enclosing an online feedback form and would request you to spare some of your valuable time to input your observations. Your esteemed input will help us in serving you better.
The link to give your feedback is: https://docs.google.com/forms/d/1fTAcdZT-vqfyzE2KkzIzI3P1ZtqSOVlpc6NObX7QT34/viewform
We thank you for your valuable time and feedback.
Thanks & Regards,
-NPTEL Team
Best of Luck for your Exam
Dear Learners,

Best of luck for your examination!
Regards
Course Admin
NPTEL Team
Immunology - Solution for Week 12 Assignment
Dear Learners,
Detailed Solution for Assignment 12 is available now in the Course Outline section. Please go through the solution and in case of any doubt post your queries in the forum.
-NPTEL Team
Exam Format - July 2020!!
-NPTEL Team
Immunology - Solution for Week 11 Assignment
Dear Learners,
Detailed Solution for Assignment 11 is available now in the Course Outline section. Please go through the solution and in case of any doubt post your queries in the forum.
-NPTEL Team
Immunology : Assignment 4 question no 2
Immunology - Week 12 Feedback Form
Dear Learners,
Thank you for enrolling to this NPTEL course and we hope you have gone through the contents for this week and also attempted the assignment.
We value your feedback and wish to know how you found the videos and the questions asked - whether they were easy, difficult, as per your expectations, etc
We shall use this to make the course better and we can also know from the feedback which concepts need more explanation, etc.
Please do spare some time to give your feedback - comprises just 5 questions - should not take more than a minute, but makes a lot of difference for us as we know what the learners feel.
Here is the link to the form: https://docs.google.com/forms/d/e/1FAIpQLSeoSyzrDDu3Lxv0DsbUdOrA4Q0mx7588rq7z6-54vbqW3HJyA/viewform
NPTEL Team
Immunology - Week 12 is live now!!
Dear Students
The lecture videos for Week 12 have been uploaded for the course Immunology. The lectures can be accessed using the following link: https://onlinecourses.nptel.ac.in/noc20_bt43/unit?unit=30&lesson=186
The other lectures of this week are accessible from the navigation bar to the left. Please remember to login into the website to view contents (if you aren't logged in already).
Assignment for Week 12 is also uploaded and can be accessed from the following link: https://onlinecourses.nptel.ac.in/noc20_bt43/unit?unit=30&assessment=181
The assignment has to be submitted on or before Wednesday, 2020-12-09, 23:59 IST .
As we have done so far, please use the discussion forums if you have any questions on this module.
--NPTEL Team
Immunology - Solution for Week 10 Assignment
Dear Learners,
Detailed Solution for Assignment 10 is available now in the Course Outline section. Please go through the solution and in case of any doubt post your queries in the forum.
-NPTEL Team
Immunology - Week 11 Feedback Form
Dear Learners,
Thank you for enrolling to this NPTEL course and we hope you have gone through the contents for this week and also attempted the assignment.
We value your feedback and wish to know how you found the videos and the questions asked - whether they were easy, difficult, as per your expectations, etc
We shall use this to make the course better and we can also know from the feedback which concepts need more explanation, etc.
Please do spare some time to give your feedback - comprises just 5 questions - should not take more than a minute, but makes a lot of difference for us as we know what the learners feel.
Here is the link to the form: https://docs.google.com/forms/d/e/1FAIpQLSeoSyzrDDu3Lxv0DsbUdOrA4Q0mx7588rq7z6-54vbqW3HJyA/viewform
NPTEL Team
Immunology - Week 11 is live now!!
Dear Students
The lecture videos for Week 11 have been uploaded for the course Immunology. The lectures can be accessed using the following link: https://onlinecourses.nptel.ac.in/noc20_bt43/unit?unit=29&lesson=176
The other lectures of this week are accessible from the navigation bar to the left. Please remember to login into the website to view contents (if you aren't logged in already).
Assignment for Week 11 is also uploaded and can be accessed from the following link: https://onlinecourses.nptel.ac.in/noc20_bt43/unit?unit=29&lesson=170
The assignment has to be submitted on or before Wednesday, 2020-12-02, 23:59 IST.
As we have done so far, please use the discussion forums if you have any questions on this module.
--NPTEL Team
Immunology - Solution for Week 9 Assignment
Dear Learners,
Detailed Solution for Assignment 9 is available now in the Course Outline section. Please go through the solution and in case of any doubt post your queries in the forum.
-NPTEL Team
Immunology - Week 10 Feedback Form
Dear Learners,
Thank you for enrolling to this NPTEL course and we hope you have gone through the contents for this week and also attempted the assignment.
We value your feedback and wish to know how you found the videos and the questions asked - whether they were easy, difficult, as per your expectations, etc
We shall use this to make the course better and we can also know from the feedback which concepts need more explanation, etc.
Please do spare some time to give your feedback - comprises just 5 questions - should not take more than a minute, but makes a lot of difference for us as we know what the learners feel.
Here is the link to the form: https://docs.google.com/forms/d/e/1FAIpQLSeoSyzrDDu3Lxv0DsbUdOrA4Q0mx7588rq7z6-54vbqW3HJyA/viewform
NPTEL Team
Immunology - Week 10 is live now!!
Dear Students
The lecture videos for Week 10 have been uploaded for the course Immunology. The lectures can be accessed using the following link: https://onlinecourses.nptel.ac.in/noc20_bt43/unit?unit=28&lesson=159
The other lectures of this week are accessible from the navigation bar to the left. Please remember to login into the website to view contents (if you aren't logged in already).
Assignment for Week 10 is also uploaded and can be accessed from the following link: https://onlinecourses.nptel.ac.in/noc20_bt43/unit?unit=28&assessment=166
The assignment has to be submitted on or before Wednesday, 2020-11-25, 23:59 IST .
As we have done so far, please use the discussion forums if you have any questions on this module.
--NPTEL Team
Immunology : Video recording on Interactive session 1
Dear All,
There was an interaction session with some of the students for the course Immunology.
The video recording is now available in the portal under the last unit "Live Interactive session"
Those who are interested can take a look.
Youtube link : https://youtu.be/36qD-_kznjg
-NPTEL Team
Immunology - Solution for Week 8 Assignment
Dear Learners,
Detailed Solution for Assignment 8 is available now in the Course Outline section. Please go through the solution and in case of any doubt post your queries in the forum.
-NPTEL Team
Immunology : Live Interactive session-1
Dear Learner,
You can interact LIVE with the Course Instructor Prof. Sudip Kumar Ghosh, Prof. Agneyo Ganguly, IIT Kharagpur – “Immunology".
Date: 11.11.2020
Time: 07:00 PM
Link to login to: https://youtu.be/xfpFNcZDOz8
Enter your questions you want
You can interact LIVE with the Course Instructor Prof. Sudip Kumar Ghosh, Prof. Agneyo Ganguly, to answer at: https://docs.google.com/forms/d/e/1FAIpQLSdd3Xk7T2DkIAA4Qxf0be_7_3VUMdbhlaQa1-uWLj0_e4Crqg/viewform
You can also ask your doubts during the session through the chat window...
We would also like to hear from you after the session. Request you to share your thoughts in the forum. Learners are encouraged to visit https://docs.google.com/spreadsheets/d/e/2PACX-1vRdbGOLmIhJl6_761LRi3OJgFmlSRK7C5qyY0JckLTc2Jx2d5kbMVrlgJmZ7yb4o0u-mrLDi8baEfK5/pubhtml
for updates on the live sessions.
-NPTEL Team
Immunology - Week 9 Feedback Form
Dear Learners,
Thank you for enrolling to this NPTEL course and we hope you have gone through the contents for this week and also attempted the assignment.
We value your feedback and wish to know how you found the videos and the questions asked - whether they were easy, difficult, as per your expectations, etc
We shall use this to make the course better and we can also know from the feedback which concepts need more explanation, etc.
Please do spare some time to give your feedback - comprises just 5 questions - should not take more than a minute, but makes a lot of difference for us as we know what the learners feel.
Here is the link to the form: https://docs.google.com/forms/d/e/1FAIpQLSeoSyzrDDu3Lxv0DsbUdOrA4Q0mx7588rq7z6-54vbqW3HJyA/viewform
NPTEL Team
Immunology - Week 9 is live now!!
Dear Students
The lecture videos for Week 9 have been uploaded for the course Immunology. The lectures can be accessed using the following link: https://onlinecourses.nptel.ac.in/noc20_bt43/unit?unit=27&lesson=150
The other lectures of this week are accessible from the navigation bar to the left. Please remember to login into the website to view contents (if you aren't logged in already).
Assignment for Week 9 is also uploaded and can be accessed from the following link: https://onlinecourses.nptel.ac.in/noc20_bt43/unit?unit=27&lesson=133
The assignment has to be submitted on or before Wednesday, 2020-11-18, 23:59 IST.
As we have done so far, please use the discussion forums if you have any questions on this module.
--NPTEL Team
Immunology - Solution for Week 7 Assignment
Dear Learners,
Detailed Solution for Assignment 7 is available now in the Course Outline section. Please go through the solution and in case of any doubt post your queries in the forum.
-NPTEL Team
Immunology - Week 8 Feedback Form
Dear Learners,
Thank you for enrolling to this NPTEL course and we hope you have gone through the contents for this week and also attempted the assignment.
We value your feedback and wish to know how you found the videos and the questions asked - whether they were easy, difficult, as per your expectations, etc
We shall use this to make the course better and we can also know from the feedback which concepts need more explanation, etc.
Please do spare some time to give your feedback - comprises just 5 questions - should not take more than a minute, but makes a lot of difference for us as we know what the learners feel.
Here is the link to the form: https://docs.google.com/forms/d/e/1FAIpQLSeoSyzrDDu3Lxv0DsbUdOrA4Q0mx7588rq7z6-54vbqW3HJyA/viewform
NPTEL Team
Immunology - Week 8 is live now!!
Dear Students
The lecture videos for Week 8 have been uploaded for the course Immunology. The lectures can be accessed using the following link: https://onlinecourses.nptel.ac.in/noc20_bt43/unit?unit=26&lesson=79
The other lectures of this week are accessible from the navigation bar to the left. Please remember to login into the website to view contents (if you aren't logged in already).
Assignment for Week 8 is also uploaded and can be accessed from the following link: https://onlinecourses.nptel.ac.in/noc20_bt43/unit?unit=26&lesson=130
The assignment has to be submitted on or before Wednesday, 2020-11-11, 23:59 IST.
As we have done so far, please use the discussion forums if you have any questions on this module.
--NPTEL Team
Immunology - Solution for Week 6 Assignment
Dear Learners,
Detailed Solution for Assignment 6 is available now in the Course Outline section. Please go through the solution and in case of any doubt post your queries in the forum.
-NPTEL Team
Immunology - Week 7 Feedback Form
Dear Learners,
Thank you for enrolling to this NPTEL course and we hope you have gone through the contents for this week and also attempted the assignment.
We value your feedback and wish to know how you found the videos and the questions asked - whether they were easy, difficult, as per your expectations, etc
We shall use this to make the course better and we can also know from the feedback which concepts need more explanation, etc.
Please do spare some time to give your feedback - comprises just 5 questions - should not take more than a minute, but makes a lot of difference for us as we know what the learners feel.
Here is the link to the form: https://docs.google.com/forms/d/e/1FAIpQLSeoSyzrDDu3Lxv0DsbUdOrA4Q0mx7588rq7z6-54vbqW3HJyA/viewform
NPTEL Team
Immunology - Week 7 is live now!!
Dear Students
The lecture videos for Week 7 have been uploaded for the course Immunology. The lectures can be accessed using the following link: https://onlinecourses.nptel.ac.in/noc20_bt43/unit?unit=25&lesson=73
The other lectures of this week are accessible from the navigation bar to the left. Please remember to login into the website to view contents (if you aren't logged in already).
Assignment for Week 7 is also uploaded and can be accessed from the following link: https://onlinecourses.nptel.ac.in/noc20_bt43/unit?unit=25&assessment=121
The assignment has to be submitted on or before Wednesday, 2020-11-04, 23:59 IST.
As we have done so far, please use the discussion forums if you have any questions on this module.
--NPTEL Team
Immunology : Feedback on Text Transcripts (English) of NPTEL videos
Immunology - Solution for Week 5 Assignment
Dear Learners,
Detailed Solution for Assignment 5 is available now in the Course Outline section. Please go through the solution and in case of any doubt post your queries in the forum.
-NPTEL Team
Immunology - Week 6 Feedback Form
Dear Learners,
Thank you for enrolling to this NPTEL course and we hope you have gone through the contents for this week and also attempted the assignment.
We value your feedback and wish to know how you found the videos and the questions asked - whether they were easy, difficult, as per your expectations, etc
We shall use this to make the course better and we can also know from the feedback which concepts need more explanation, etc.
Please do spare some time to give your feedback - comprises just 5 questions - should not take more than a minute, but makes a lot of difference for us as we know what the learners feel.
Here is the link to the form: https://docs.google.com/forms/d/e/1FAIpQLSeoSyzrDDu3Lxv0DsbUdOrA4Q0mx7588rq7z6-54vbqW3HJyA/viewform
NPTEL Team
Immunology - Week 6 is live now!!
Dear Students
The lecture videos for Week 6 have been uploaded for the course Immunology. The lectures can be accessed using the following link: https://onlinecourses.nptel.ac.in/noc20_bt43/unit?unit=24&lesson=65
The other lectures of this week are accessible from the navigation bar to the left. Please remember to login into the website to view contents (if you aren't logged in already).
Assignment for Week 6 is also uploaded and can be accessed from the following link: https://onlinecourses.nptel.ac.in/noc20_bt43/unit?unit=24&assessment=117
The assignment has to be submitted on or before Wednesday, 2020-10-28, 23:59 IST.
As we have done so far, please use the discussion forums if you have any questions on this module.
--NPTEL Team
Immunology - Solution for Week 4 Assignment
Dear Learners,
Detailed Solution for Assignment 4 is available now in the Course Outline section. Please go through the solution and in case of any doubt post your queries in the forum.
-NPTEL Team
Immunology - Week 5 Feedback Form
Dear Learners,
Thank you for enrolling to this NPTEL course and we hope you have gone through the contents for this week and also attempted the assignment.
We value your feedback and wish to know how you found the videos and the questions asked - whether they were easy, difficult, as per your expectations, etc
We shall use this to make the course better and we can also know from the feedback which concepts need more explanation, etc.
Please do spare some time to give your feedback - comprises just 5 questions - should not take more than a minute, but makes a lot of difference for us as we know what the learners feel.
Here is the link to the form: https://docs.google.com/forms/d/e/1FAIpQLSeoSyzrDDu3Lxv0DsbUdOrA4Q0mx7588rq7z6-54vbqW3HJyA/viewform
NPTEL Team
Immunology - Week 5 is live now!!
Dear Students
The lecture videos for Week 5 have been uploaded for the course Immunology. The lectures can be accessed using the following link: https://onlinecourses.nptel.ac.in/noc20_bt43/unit?unit=23&lesson=58
The other lectures of this week are accessible from the navigation bar to the left. Please remember to login into the website to view contents (if you aren't logged in already).
Assignment for Week 5 is also uploaded and can be accessed from the following link: https://onlinecourses.nptel.ac.in/noc20_bt43/unit?unit=23&assessment=112
The assignment has to be submitted on or before Wednesday, 2020-10-21, 23:59 IST.
As we have done so far, please use the discussion forums if you have any questions on this module.
--NPTEL Team
Immunology - Solution for Week 3 Assignment
Dear Learners,
Detailed Solution for Assignment 3 is available now in the Course Outline section. Please go through the solution and in case of any doubt post your queries in the forum.
-NPTEL Team
Immunology - Week 4 Feedback Form
Dear Learners,
Thank you for enrolling to this NPTEL course and we hope you have gone through the contents for this week and also attempted the assignment.
We value your feedback and wish to know how you found the videos and the questions asked - whether they were easy, difficult, as per your expectations, etc
We shall use this to make the course better and we can also know from the feedback which concepts need more explanation, etc.
Please do spare some time to give your feedback - comprises just 5 questions - should not take more than a minute, but makes a lot of difference for us as we know what the learners feel.
Here is the link to the form: https://docs.google.com/forms/d/e/1FAIpQLSeoSyzrDDu3Lxv0DsbUdOrA4Q0mx7588rq7z6-54vbqW3HJyA/viewform
NPTEL Team
Immunology - Week 4 is live now!!
Dear Students
The lecture videos for Week 4 have been uploaded for the course Immunology. The lectures can be accessed using the following link: https://onlinecourses.nptel.ac.in/noc20_bt43/unit?unit=20&lesson=52
The other lectures of this week are accessible from the navigation bar to the left. Please remember to login into the website to view contents (if you aren't logged in already).
Assignment for Week 4 is also uploaded and can be accessed from the following link: https://onlinecourses.nptel.ac.in/noc20_bt43/unit?unit=20&assessment=107
The assignment has to be submitted on or before Wednesday, 2020-10-14, 23:59 IST.
As we have done so far, please use the discussion forums if you have any questions on this module.
--NPTEL Team
Exam Registration form is open now - Register today!!!!
Dear Learner,
Here is the much-awaited announcement on registering for the July 2020 NPTEL course certification exam.
1. The registration for the certification exam is open only to those learners who have enrolled in the course.
2. If you want to register for the exam for this course, login here using the same email id which you had used to enroll to the course in Swayam portal. Please note that Assignments submitted through the exam registered email id ALONE will be taken into consideration towards final consolidated score & certification.
3. Date of exam: December 20, 2020
Certification exam registration URL is: https://examform.nptel.ac.in/
Choose from the Cities where exam will be conducted: Exam Cities
4. Exam fees:
If you register for the exam and pay before Oct 28, 10:00 AM, Exam fees will be Rs. 1000/- per exam.
If you register for exam before Oct 28, 10:00 AM and have not paid or if you register between Oct 28, 10:00 AM & Nov 02, 5:00 PM, Exam fees will be Rs. 1500/- per exam
5. 50% fee waiver for the following categories:
Students belonging to the SC/ST category: please select Yes for the SC/ST option and upload the correct Community certificate.
Students belonging to the PwD category with more than 40% disability: please select Yes for the option and upload the relevant Disability certificate.
6. Last date for exam registration: Nov 02, 2020 5:00 PM (Friday).
7. Mode of payment: Online payment - debit card/credit card/net banking.
8. HALL TICKET:
The hall ticket will be available for download tentatively by 2 weeks prior to the exam date - between December 10-15, 2020. We will confirm the same through an announcement once it is published.
9. FOR CANDIDATES WHO WOULD LIKE TO WRITE MORE THAN 1 COURSE EXAM:- you can add or delete courses and pay separately – till the date when the exam form closes. Same day of exam – you can write exams for 2 courses in the 2 sessions. Same exam center will be allocated for both the sessions.
10. Data changes:
Last date for data changes: 02 Nov 2020, 5:00 PM:
All the fields in the Exam form except for the following ones can be changed until the form closes.
The following 6 fields can be changed ONLY when there are NO courses in the course cart.
And you will be able to edit the following fields only if you:
-
REMOVE unpaid courses from the cart
And/or
- CANCEL paid courses
1. Do you come under the SC/ST category? *
2. SC/ST Proof
3. Are you a person with disabilities? *
4. Are you a person with disabilities above 40%?
5. Disabilities Proof
6. What is your role ?
Note: Once you remove or cancel a course, you will be able to edit these fields immediately.
But, for cancelled courses, refund of fees will be initiated only after 2 weeks.
11. LAST DATE FOR CANCELLING EXAMS and getting a refund: 02 Nov 2020, 5:00 PM
12. Click here to view Timeline and Guideline : Guideline
Thanks & Regards,
NPTEL TEAM
Immunology - Solution for Week 1 & 2 Assignment
Dear Learners,
Detailed Solution for Assignment 1 & 2 are available now in the Course Outline section. Please go through the solution and in case of any doubt post your queries in the forum.
-NPTEL Team
Reg: Assignment 1 question no 6
Immunology - Week 3 Feedback Form
Dear Learners,
Thank you for enrolling to this NPTEL course and we hope you have gone through the contents for this week and also attempted the assignment.
We value your feedback and wish to know how you found the videos and the questions asked - whether they were easy, difficult, as per your expectations, etc
We shall use this to make the course better and we can also know from the feedback which concepts need more explanation, etc.
Please do spare some time to give your feedback - comprises just 5 questions - should not take more than a minute, but makes a lot of difference for us as we know what the learners feel.
Here is the link to the form: https://docs.google.com/forms/d/e/1FAIpQLSeoSyzrDDu3Lxv0DsbUdOrA4Q0mx7588rq7z6-54vbqW3HJyA/viewform
NPTEL Team
Immunology - Week 3 is live now!!
Dear Students
The lecture videos for Week 3 have been uploaded for the course Immunology. The lectures can be accessed using the following link: https://onlinecourses.nptel.ac.in/noc20_bt43/unit?unit=22&lesson=43
The other lectures of this week are accessible from the navigation bar to the left. Please remember to login into the website to view contents (if you aren't logged in already).
Assignment for Week 3 is also uploaded and can be accessed from the following link: https://onlinecourses.nptel.ac.in/noc20_bt43/unit?unit=22&assessment=104
The assignment has to be submitted on or before Wednesday, 2020-10-07, 23:59 IST.
As we have done so far, please use the discussion forums if you have any questions on this module.
--NPTEL Team
Immunology - Week 2 Feedback Form
Dear Learners,
Thank you for enrolling to this NPTEL course and we hope you have gone through the contents for this week and also attempted the assignment.
We value your feedback and wish to know how you found the videos and the questions asked - whether they were easy, difficult, as per your expectations, etc
We shall use this to make the course better and we can also know from the feedback which concepts need more explanation, etc.
Please do spare some time to give your feedback - comprises just 5 questions - should not take more than a minute, but makes a lot of difference for us as we know what the learners feel.
Here is the link to the form: https://docs.google.com/forms/d/e/1FAIpQLSeoSyzrDDu3Lxv0DsbUdOrA4Q0mx7588rq7z6-54vbqW3HJyA/viewform
NPTEL Team
Immunology - Download video links are available now!!
Dear Learners,
The download video links for the course Immunology are available now in the course outline. Please check the download video link: https://nptel.ac.in/courses/102/105/102105083/
-NPTEL Team
Immunology - Week 2 is live now!!
Dear Students
The lecture videos for Week 2 have been uploaded for the course Immunology. The lectures can be accessed using the following link: https://onlinecourses.nptel.ac.in/noc20_bt43/unit?unit=21&lesson=37
The other lectures of this week are accessible from the navigation bar to the left. Please remember to login into the website to view contents (if you aren't logged in already).
Assignment for Week 2 is also uploaded and can be accessed from the following link: https://onlinecourses.nptel.ac.in/noc20_bt43/unit?unit=21&assessment=101
The assignment has to be submitted on or before Wednesday, 2020-09-30, 23:59 IST.
As we have done so far, please use the discussion forums if you have any questions on this module.
--NPTEL Team
Immunology - Week 1 assignment is live now!!
Dear Learners,
The assignment for Week 1 for the course Immunology is made available early for viewing to get an idea about the assignments but the actual start date of the course remains unchanged.
Assignment 1 can be accessed using the following link: https://onlinecourses.nptel.ac.in/noc20_bt43/unit?unit=18&assessment=94
The other Assignment 1 is accessible from the navigation bar to the left under Week 1. Please remember to login into the website to view contents (if you aren't logged in already).
The assignment has to be submitted on or before Wednesday, 2020-09-30, 23:59 IST.
Please use the discussion forums if you have any questions on this module.
Happy Learning!
-NPTEL Team
Immunology - Week 1 Feedback Form
Dear Learners,
Thank you for enrolling to this NPTEL course and we hope you have gone through the contents for this week and also attempted the assignment.
We value your feedback and wish to know how you found the videos and the questions asked - whether they were easy, difficult, as per your expectations, etc
We shall use this to make the course better and we can also know from the feedback which concepts need more explanation, etc.
Please do spare some time to give your feedback - comprises just 5 questions - should not take more than a minute, but makes a lot of difference for us as we know what the learners feel.
Here is the link to the form: https://docs.google.com/forms/d/e/1FAIpQLSeoSyzrDDu3Lxv0DsbUdOrA4Q0mx7588rq7z6-54vbqW3HJyA/viewform
NPTEL Team
Immunology - Week 1 videos are live now!!
Dear Learners,
The videos for Week 1 for the course Immunology is made available early for viewing to get an idea about the content but the actual start date remains unchanged.
The lectures can be accessed using the following link: https://onlinecourses.nptel.ac.in/noc20_bt43/unit?unit=18&lesson=32 The other lectures of this week are accessible from the navigation bar to the left. Please remember to login into the website to view contents (if you aren't logged in already).
Please use the discussion forums if you have any questions on this module.
Happy Learning!
--NPTEL Team
Immunology : Course is now available for NPTEL Domain Certification
Dear Learner
Have you decided which NPTEL domain you wish to pursue and specialise in?
You would have seen an earlier post from us about what an NPTEL domain is.
Do you know that this course you are enrolled to is part of the domain " Biosciences"??
We have other courses that are part of this domain also being offered this semester and are open for enrollment.
Please check the link https://nptel.ac.in/noc/Domain/discipline/102/102_2.html to know more, so that you can enroll to other courses and attempt at earning the prestigious NPTEL Domain Certification.
Visit the URL to know who have completed NPTEL Domains so far: https://nptel.ac.in/nptelStars/DomainScholars.html
-NPTEL team
Want to specialize? Complete an NPTEL Domain!!
Dear Learner
NPTEL Provides 41 Domains across 10 Disciplines which makes learners an expert in a particular area.
Gear up for the Future, acing the competitive exam or becoming Job ready by specialising in an area of study.
For more details visit: https://nptel.ac.in/noc/Domain/
Watch the short informative video on this: https://youtu.be/
Stay Tuned for more exciting things.
-NPTEL Team
NPTEL : Keep in touch with us via Social Media
Dear Learner
You already must know NPTEL is providing course certificates to those who complete the course successfully, with the learning happening right at your home or where you are. But NPTEL also keeps bringing out new initiatives and courses - which we would like to keep you posted on.
Click the below links to like and follow us on Social Media for instant Updates:
Facebook: https://www.facebook.com/NPTELNoc
Twitter: https://twitter.com/nptelindia
Linkedin: https://www.linkedin.com/in/nptel-india-085866ba/
Instagram: https://www.instagram.com/swayam_nptel/
Like and Follow us on Social Media. Let's create a better future by learning and growing together.
-NPTEL Team.
Welcome to NPTEL Online Course: Immunology
Welcome to SWAYAM-NPTEL Online Courses and Certification!
Thank you for signing up for our online course "Immunology". We wish you an enjoyable and informative learning experience.
*****REVISED START DATE AND EXAM DATE FOR JULY 2020****
Details regarding the course:
Name of the course: Immunology
Course url: https://swayam.gov.in/
Course duration : 12 weeks
The course will begin on 14 September 2020 When content is released on the portal, you will get an email alerting you.
CONTENT AND ASSIGNMENTS
Every week, about 2.5 to 4 hours of videos containing content by the Course instructor will be released along with an assignment based on this. Please watch the lectures, follow the course regularly and submit all assessments and assignments before the due date. Your regular participation is vital for learning and doing well in the course. This will be done week on week through the duration of the course.
Please do the assignments yourself and even if you take help, kindly try to learn from it. These assignment will help you prepare for the final exams. Plagiarism and violating the Honor code will be taken very seriously if detected during the submission of assignments.
ANNOUNCEMENT AND DISCUSSION GROUPS TO CLEAR DOUBTS:
The announcement group - will only have messages from course instructors and teaching assistants - regarding the lessons, assignments, exam registration, hall tickets etc.
The discussion forum (Ask a question tab on the portal) - is for everyone to ask questions and interact.Anyone who knows the answers can reply to anyone's post and the course instructor/TA will also respond to your queries. Please make maximum use of this feature as this will help you learn much better.
If you have any questions regarding the exam, registration, hall tickets, results, queries related to the technical content in the lectures, any doubts in the assignments, etc can be posted in the forum section
TO GET A CERTIFICATE - PROCESS AND CRITERIA:
The course is free to enroll and learn from. But if you want a certificate, you have to register and write the proctored exam conducted by us in person at any of the designated exam centres.
The exam is optional for a fee of Rs 1000/- (Rupees one thousand only).
Date and Time of Exams: 20 December 2020 Morning session 9am to 12 noon; Afternoon Session 2pm to 5pm.
Registration url: Announcements will be made when the registration form is open for registrations.
The online registration form has to be filled and the certification exam fee needs to be paid. More details will be made available when the exam registration form is published. If there are any changes, it will be mentioned then.
Please check the form for more details on the cities where the exams will be held, the conditions you agree to when you fill the form etc.
CRITERIA TO GET A CERTIFICATE
- Average assignment score = 25% of average of best 8 assignments out of the total 12 assignments given in the course.
- Exam score = 75% of the proctored certification exam score out of 100
- Final score = Average assignment score + Exam score
YOU WILL BE ELIGIBLE FOR A CERTIFICATE ONLY IF AVERAGE ASSIGNMENT SCORE >=10/25 AND EXAM SCORE >= 30/75. If one of the 2 criteria is not met, you will not get the certificate even if the Final score >= 40/100.
Certificate will have your name, photograph and the score in the final exam with the breakup.It will have the logos of NPTEL and IIT Kharagpur .It will be e-verifiable at nptel.ac.in/noc.
Only the e-certificate will be made available. Hard copies will not be dispatched.
Once again, thanks for your interest in our online courses and certification. Happy learning.
- NPTEL team
Immunology - Assignment 0 Deadline EXTENDED
Dear Learners,
As you are aware that the July-Dec courses start date has been postponed to September 14, 2020. So we have extended the due date of the assignment 0 of the course Immunology . Kindly note that marks obtained in this assignment will not be considered for the final assessment. You can find the assignment under Week 0 unit on the left-hand side of your screen You can submit the assignment multiple times before the due date. All the best !!
The extended due date of Assignment 0: 14-09-2020, 23:59 hrs.
--NPTEL Team
Immunology - Assignment-0-RELEASED
Dear Learners,
We welcome you all to this course. The assignment 0 for the course Immunology has been released. This assignment is based on a prerequisite of the course. Kindly note that marks obtained in this assignment will not be considered for the final assessment. You can find the assignment under Week 0 unit on the left-hand side of your screen You can submit the assignment multiple times before the due date. All the best !!
The due date of Assignment 0: 2020-07-20, 23:59 IST
--NPTEL Team



